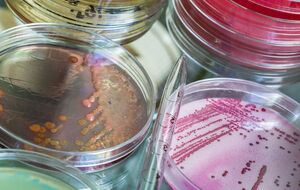
Россия может попытаться обвинить Украину в "применении биологического оружия", считают в ГУР

холера

В Африке – самая сильная вспышка холеры за 25 лет. Умерло уже более 7 тыс. человек
14 ноября, 08.20
Мир
В Польше зафиксирован первый за шесть лет случай холеры. Заболевшая – в тяжелом состоянии, десятки человек – на карантине
20 июля, 18.45
Мир
В Мьянме зафиксировали новые землетрясения. Число жертв в результате предыдущего может достичь 3 тыс. людей
1 апреля, 15.58
Мир
Оккупационные власти скрывают вспышку холеры в Крыму – Центр нацсопротивления
30 июля, 14.25
Общество
В оккупированной Авдеевке вспыхнула эпидемия холеры, город закрыт на въезд и выезд – Барабаш
26 июля, 10.32
События
Выключения света могут привести к вспышке инфекционных болезней, в частности гепатита и холеры – Ляшко
20 июня, 16.22
Общество
"Холеру не обнаружили". В Минздраве Украины сообщили о завершении ликвидации последствий теракта РФ на Каховской ГЭС
4 сентября, 20.38
Общество
В харьковском озере найден холерный вибрион. На время перепроверки озеро закрыто для рыбаков и купания
4 августа, 17.37
Общество
Оккупанты замалчивают вспышку холеры в Херсонской области и проводят скрытую вакцинацию коллаборантов – Генштаб ВСУ
5 июля, 08.22
Война в Украине
Холеры на пострадавших от наводнения территориях нет, это фейк – Минздрав Украины
26 июня, 23.55
Общество
Голубовская: Холера – тяжелейшее заболевание, которое протекает с нормальной температурой. И болей в животе никаких нет
21 июня, 14.40
Общество
Лихорадка Западного Нила – одно из заболеваний, вспышки которых могут произойти из-за подрыва Каховской ГЭС. Эта болезнь плохо диагностируется, но встречается на нашей территории – Голубов
20 июня, 08.00
События
В водоемах Николаевской области обнаружили холероподобный вибрион – Минздрав
19 июня, 15.17
Война в Украине
В Одессе запретили купаться и ловить рыбу во всех водоемах из-за угрозы инфекций
17 июня, 13.10
Общество
Минздрав Украины опроверг, что в южных регионах, затопленных после подрыва ГЭС, обнаружили холеру
13 июня, 17.47
Происшествия
В Госэкоинспекции заявили, что на территории, затопленной после подрыва Каховской ГЭС, обнаружили кишечную палочку и холеру, но потом опровергли информацию
13 июня, 16.37
Происшествия
ВОЗ предупредила о "высоком риске биологической опасности" в Судане из-за захвата лаборатории
25 апреля, 21.59
Мир
Минздрав Украины не исключает вероятность вспышки холеры на оккупированных территориях
16 июня, 10.39
Общество
Мэр Мариуполя заявил, что в городе началась холера: Может унести тысячи жизней
15 июня, 01.11
Общество
В Украине не зафиксировано случаев холеры, риски распространения инфекций в Мариуполе растут – Минздрав
12 июня, 17.34
Война в Украине
От дизентерии, холеры и других инфекционных болезней до конца года может умереть 10 тыс. мариупольцев – мэр
10 июня, 22.12
Общество
Оккупанты запретили жителям Мариуполя купаться в Азовском море – горсовет
7 июня, 19.35
Война в Украине
Из-за войны через пять – семь лет в Украине будет бум онкологических, инфекционных и сердечно-сосудистых заболеваний – Ляшко
7 июня, 18.29
Война в Украине
"Россия выбрала самый циничный сценарий из всех возможных". Оккупанты хотят закрыть Мариуполь из-за холеры – мэрия
6 июня, 17.56
Война в Украине
В Мариуполе возможны вспышки ряда заболеваний, в том числе холеры – ВОЗ
18 мая, 13.07
Война в Украине
РФ готовится к эпидемии холеры в приграничных с Украиной областях и в Крыму, возможны провокации – ГУР Минобороны
2 мая, 18.39
Война в Украине
Жителям Мариуполя из-за антисанитарии угрожают эпидемии холеры, дизентерии и кишечной палочки – горсовет
29 апреля, 00.26
Война в Украине
Украинские миротворцы в ДР Конго оказались в эпицентре эпидемии брюшного тифа и холеры, на доставку вакцины уйдет несколько недель – СМИ
12 августа, 17.37
ПроисшествияПоказать больше
Предыдущая
1
2
Следующая



















